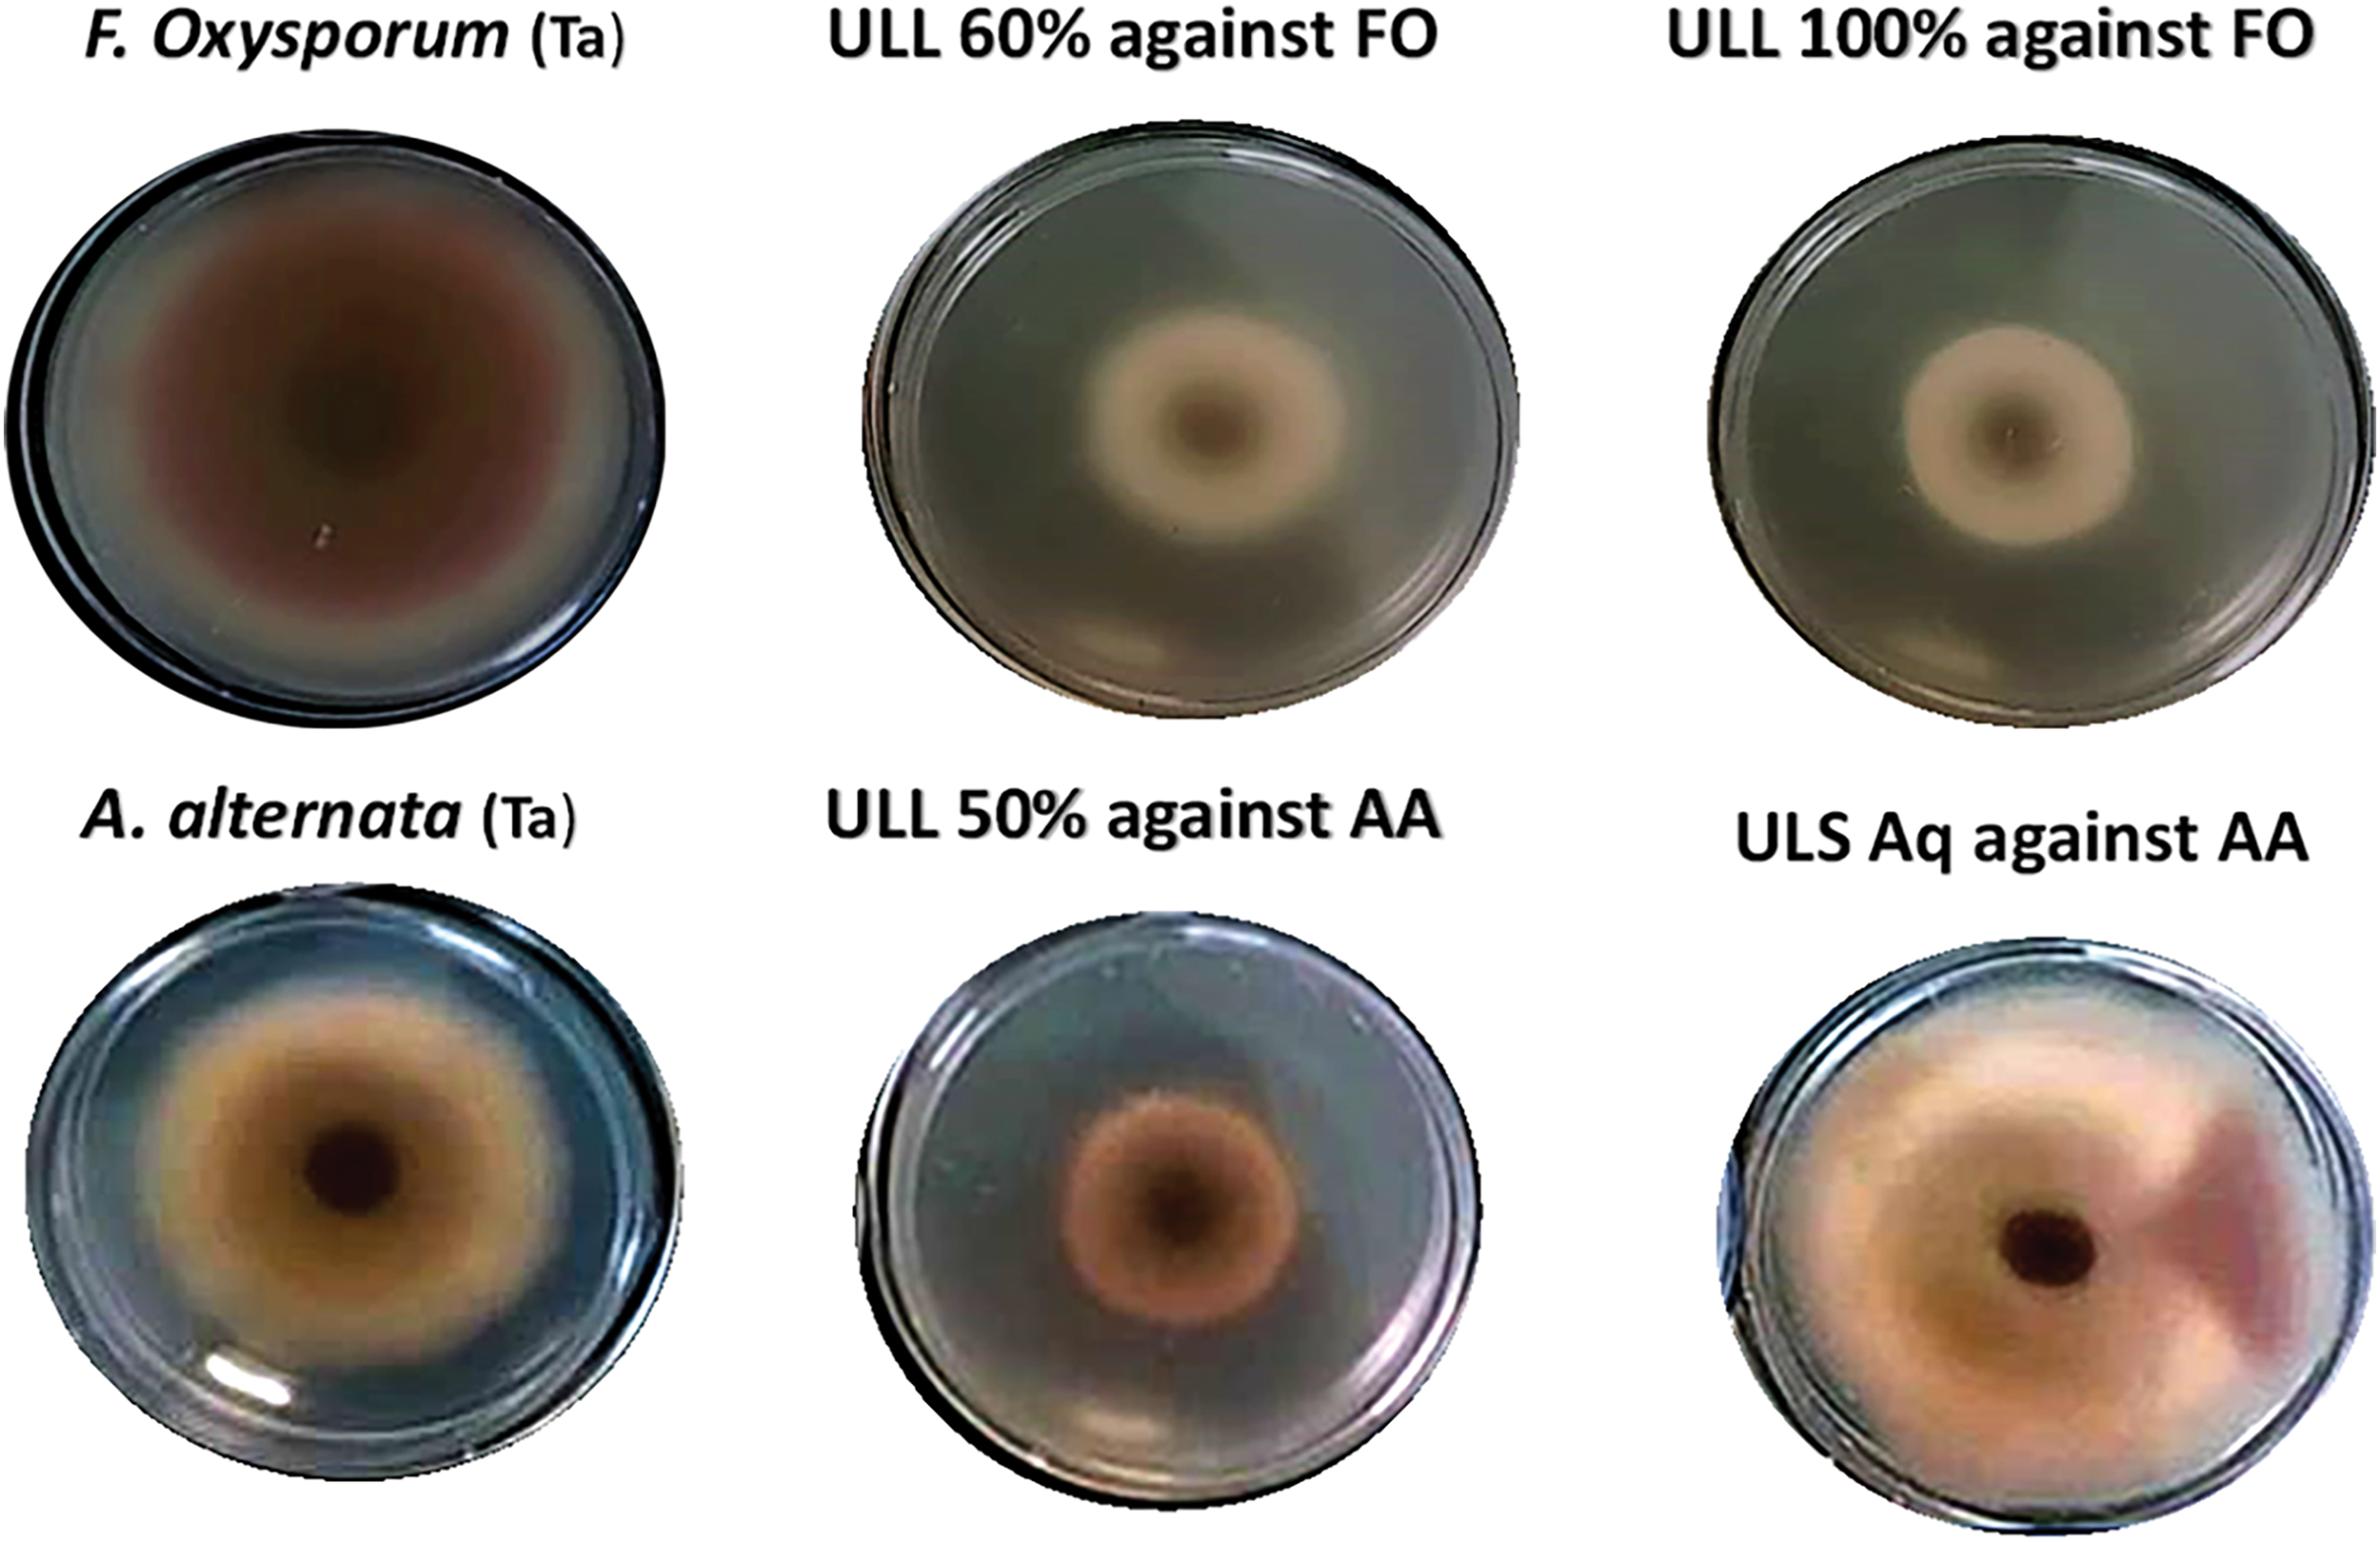
images

Open Access
ARTICLE
Bioactive Compounds Recovery from Larrea tridentata by Green Ultrasound-Assisted Extraction
1 Bioprocesses and Bioproducts Research Group, Food Research Department, School of Chemistry, Universidad Autónoma de Coahuila, Saltillo, 25070, Mexico
2 Centro de Investigacion e Innovacion Científica y Tecnológica, Universidad Autónoma de Coahuila, Saltillo, 25070, México
* Corresponding Author: Cristóbal Noe Aguilar. Email:
Phyton-International Journal of Experimental Botany 2024, 93(11), 3091-3107. https://doi.org/10.32604/phyton.2024.058422
Received 12 September 2024; Accepted 30 October 2024; Issue published 30 November 2024
Abstract
Postharvest losses remain a significant challenge, particularly in developing countries that have inadequate infrastructure. Medicinal plants offer an eco-friendly and sustainable solution for managing diseases and pests in agricultural systems. These plants are rich in bioactive compounds, such as alkaloids, flavonoids, terpenoids, phenolics, and essential oils, many of which have proven antimicrobial, antifungal, insecticidal, and antioxidant properties. These characteristics make medicinal plants viable candidates for postharvest disease and pest control. Among these, Larrea tridentata (creosote bush) is particularly notable for its bioactive compounds with strong antifungal properties. Their potential applications include agriculture, food preservation, and medicine. This study aimed to evaluate how different solvent mixtures affect the efficiency of ultrasound-assisted extraction, total polyphenol content, antioxidant capacity, and antifungal activity of L. tridentata leaves and stems. The findings revealed that the 60% ethanol ultrasound-assisted extract of L. tridentata leaves (ULL 60%) contained the highest concentration of bioactive compounds, including hydrolysable tannins (690.2 mg GAE/100 g) and condensed tannins (329.9 mg CE/100 g). All extracts demonstrated notable antioxidant activity in ABTS, DPPH, and FRAP assays, with ethanol-based extracts showing greater antioxidant potential than their aqueous counterparts. In terms of antifungal efficacy, 100% ethanol leaf extract exhibited the strongest inhibition against Fusarium oxysporum (60.03%), whereas 50% ethanol extract effectively inhibited Alternaria alternata (53.61%). Six major polyphenolic compounds were identified using reverse-phase high-performance liquid chromatography coupled with electrospray ionization mass spectrometry (RP-HPLC-ESI-MS). These include quercetin, luteolin, 3,4-dihydroxyphenylethanol, elenolic acid, nordihydroguaiaretic acid (NDGA), and kaempferide. These compounds are known to have antibacterial, antifungal and antioxidant properties. These findings underscore the potent fungistatic properties of L. tridentata leaf extracts against key phytopathogenic fungi, highlighting their potential as bioactive agents in the formulation of eco-friendly biopesticides.Graphic Abstract
Keywords
Postharvest losses pose significant challenges to agricultural productivity, particularly in developing regions that lack the appropriate infrastructure for handling, storage, and transport. These losses are primarily caused by microbial infections, pest infestations, and oxidative spoilage [1,2]. Traditionally, synthetic chemicals are used to manage postharvest diseases and pests. However, growing concerns about environmental damage, human health risks, and the rise of resistant pathogens have prompted a shift towards natural, sustainable alternatives [3,4].
Medicinal plants are effective and sustainable alternatives for controlling postharvest diseases. These plants are rich in bioactive compounds such as alkaloids, flavonoids, terpenoids, phenolics, and essential oils, which target various pathogens through distinct mechanisms. For instance, their antimicrobial and antifungal properties inhibit the growth of harmful microorganisms, whereas their antioxidant activity protects against oxidative spoilage. In addition, certain compounds exhibit insecticidal effects, making medicinal plants a multifunctional tool for postharvest management [5]. As a result, they have great potential for combating postharvest spoilage.
However, the effectiveness of these bioactive compounds depends largely on the extraction method. Although, conventional extraction techniques suffer from limitations such as low selectivity, high energy consumption, and the risk of thermal degradation of compounds [6–9]. Additionally, reliance on organic solvents and extended extraction times raises environmental and safety concerns, making these methods less suitable for large-scale industrial applications. Inconsistent conditions and batch-to-batch variability further hinder their practicality processes [10,11].
In contrast, eco-friendly extraction techniques such as ultrasound-assisted extraction (UAE) offer a sustainable alternative. UAE uses ultrasonic waves to efficiently break down plant cell walls, allowing for the faster and more efficient extraction of bioactive compounds [12,13]. This method reduces extraction time while preserving the molecular integrity of the compounds. UAE’s high yield, environmental friendliness, and scalability of UAE make it an attractive approach for the extraction of natural products [14–16].
Studies have demonstrated the advantages of UAE. For instance, Khursheed et al. [17] found that ultrasonication, combined with methanol, improved the yield of bioactive compounds from Centella asiatica leaves, enhancing antioxidant activity.
Keskin Çavdar et al. [18] optimized UAE of Inula viscosa, achieving higher phenolic and flavonoid content compared to conventional methods, which in turn improved antioxidant activity. Similarly, Chen et al. [19] optimized the dual-frequency UAE of polysaccharides from Pithecellobium clypearia, achieving significant biological activity, such as antioxidant and hypoglycemic effects.
Larrea tridentata is a promising plant for managing postharvest diseases and is native to the arid regions of North and South America. This hardy shrub produces several bioactive compounds that enhance its survival under extreme conditions, particularly polyphenols, which are known to have antifungal properties [20].
These polyphenols, such as flavonoids (quercetin and luteolin) and phenolic acids (caffeic and gallic), disrupt fungal membranes, inhibit enzymes, and induce oxidative stress, ultimately leading to fungal cell death [21–23].
In addition to their antifungal effects, polyphenols extend the shelf life of perishable foods by preventing microbial growth and oxidative damage. Incorporating extracts from L. tridentata into edible coatings has shown potential for preserving delicate fruits, such as blueberries by up to 5 days [24,25].
Núñez-Mojica et al. [26] isolated two cyclolignans and six known compounds from L. tridentata’s chloroform extract. The compounds were characterized for antibacterial and cytotoxic activities against drug-resistant bacteria, Mycobacterium tuberculosis, and cancer cell lines, with methylated derivative being the most active.
The extract obtained from L. tridentata using UAE will have a significantly higher concentration of polyphenolic compounds, which will effectively inhibit the growth of F. oxysporum and A. alternata.
This study aimed to evaluate the effectiveness of various solvent mixtures in extracting polyphenols from L. tridentata, quantify their total polyphenol content, and assess their antifungal and antioxidant capacities.
These findings could lead to sustainable postharvest control methods, reducing dependence on synthetic chemicals.
The following materials were acquired from Sigma Aldrich (Toluca, Mexico) in analytical grade: ethanol, distilled water, potato dextrose agar, gallic acid, quercetin, 6-hydroxy-2,5,7,8-tetramethylchroman-2-carboxylic acid (Trolox), 2,2-diphenyl-1-picrylhydrazyl (DPPH), 2,2′-azino-bis(3-ethylbenzthiazoline-6-sulphonic acid) (ABTS), 2,4,6-tripyridyl-s-triazine (TPTZ), Tween 80, and Folin-Ciocalteu reagent. Additionally, anhydrous sodium carbonate (Na2CO3), sodium hydroxide (NaOH), sodium nitrite (NaNO2), aluminum chloride (AlCl3), hydrochloric acid (HCl), and ammonium ferric sulfate ([FeNH4(SO4)2·12H2O]) were purchased.
In February 2023, whole plants of L. tridentata were collected from Parras de la Fuente, Coahuila, Mexico (25°10′59.3″ N, 102°45′41.2″ W). The leaves and stems were manually separated, washed with distilled water, and air-dried under controlled laboratory conditions for 14 days. The dried plant materials were then ground into powder using an automated grinder at the Department of Biotechnology, Faculty of Chemical Sciences, Autonomous University of Coahuila, Mexico. The powdered samples were stored in light-proof plastic bags at 4°C to prevent light-induced degradation until further use.
2.3 Extraction of Bioactive Compounds
2.3.1 Ultrasound Assisted Extraction of Polyphenols
The extraction process followed a modified version of the method described by [27]. A Branson Scientific Ultrasonic 2510 instrument, operating at 37°C and 40 kHz, was used for extraction. The water temperature in the ultrasonic bath was continuously monitored with a mercury thermometer to ensure precise control. A solid-to-liquid ratio of 1:5 (w/v) was maintained, with 5 g of leaf or stem material extracted in 250 mL of solvent for 1 h. Solvent systems with varying water-to-ethanol ratios (100:0, 50:50, 40:60, 0:100, v/v) were employed. The extracts were concentrated using a rotary evaporator (Model RV 10 D S99, IKA, Guangzhou, China) and stored at 4°C to prevent compound degradation prior to further analysis.
The percentage yield of each extract was determined using Eq. (1).
2.4 Quantification of Hydrolysable and Condensed Tannins
The polyphenolic compound content in the extracts was assessed using the Folin-Ciocalteu reagent, following modifications of the method described by [28]. This redox assay evaluates phenolic content based on reducing capacity. A mixture of 25 µL of diluted extract, 25 µL of Folin-Ciocalteu reagent, and 25 µL of 0.7 M sodium carbonate was prepared, and the reaction was allowed to proceed for 5 min and 125 µL of distilled water was finally added. The absorbance was measured at 750 nm using a UV-visible Epoch TM Microplate Spectrophotometer. Results were obtained by linear regression from a calibration curve and expressed as milligrams of gallic acid equivalents per milligram of dry weight (DW) sample (mg GAE/100 g DW).
Condensed tannins were quantified using the method described by [29]. A mixture of 250 µL of water, 1.5 mL of HCl:Butanol (1:9), and 1 mL of ferric reagent was heated at 95°C for 45 min in a covered vessel. After cooling for 30 min, the absorbance was measured at 460 nm with the same spectrophotometer to determine catechin equivalents per milligram of dry weight (DW) sample (mg CE/100 g DW), based on a calibration curve.
2.5 Antifungal Assay of the Extracts
The antifungal activities of the extracts against F. oxysporum and A. alternata were evaluated using a modified version of the method described by Osman Mohamed Ali et al. [30]. Sterilized potato dextrose agar (PDA) was melted and cooled before 500 µL of the extract was aseptically mixed into the medium under laminar flow conditions. The positive control contained only inoculated fungal cultures without any extract, whereas the solvents used for extraction served as negative controls. After solidification, a 5 mm fungal culture disc was placed at the centre of each plate. Plates were incubated at 25°C ± 1°C until full fungal growth was observed in the control plates (5–8 days). Each experiment was performed in triplicate, and the fungal mycelial growth (mm) was measured in three different directions. The percentage inhibition of radial growth was calculated using the following Eq. (2).
DC = Growth of fungus in control.
DT = Growth of fungus in treatment.
2.6 Antioxidant Activity in the Extracts
The antioxidant capacity of the extracts was evaluated using three different assays: 2,2-diphenyl-1-picrylhydrazyl (DPPH) radical scavenging, 2,2′-azino-bis (3-ethylbenzothiazoline-6-sulfonic acid) (ABTS), and ferric reducing antioxidant power (FRAP).
2.6.1 DPPH Radical Scavenging Assay
The DPPH assay was performed following the methodology proposed by [31], with minor modifications. A 60 mM DPPH radical solution in methanol was used to evaluate the electron donation capacity of the samples. For each microplate well, 193 µL of DPPH radical was added to 7 µL of the sample or standard curve (gallic acid). The reaction mixture was incubated in the dark for 30 min, and the absorbance was recorded at 517 nm using a UV-visible Epoch™ Microplate Spectrophotometer. Trolox was used as a standard, and results were expressed as milligrams of Trolox equivalents per gram of extract (mg TEAC/g).
2.6.2 Ferric Reducing Antioxidant Power (FRAP) Assay
The FRAP assay was conducted according to the protocol described by [32] with modifications. The FRAP reagent was prepared by mixing 2.5 mL of a 10 mM TPTZ solution in 40 mM HCl, 2.5 mL of 20 mM FeCl3, and 2.5 mL of 0.3 M acetate buffer (pH 3.6). The assay was performed by combining the sample (Trolox as a standard) with 290 µL of the FRAP reagent, which was then incubated in the dark for 15 min. The absorbance was measured at 593 nm using a UV-visible Epoch™ Microplate Spectrophotometer. The results were expressed as milligrams of Trolox equivalents per gram of sample (mg TEAC/g).
The ABTS assay was conducted using the method described by Bautista-Hernández et al. [33] with modification. 7 mM solution of ABTS was prepared by mixing with 2.45 mM K2S2O8. The mixture was incubated at room temperature in the dark for 12–16 h, then diluted with ethanol to achieve an absorbance of 0.7 ± 0.02 at 734 nm. ABTS ethanol solution (190 µL) was mixed with 10 µL of the extracts and allowed to react for 1 min before measuring the absorbance at 734 nm using a microplate reader (Epoch, BioTek Instruments, USA). The antioxidant activity of L. tridentata extract was evaluated using Trolox as a positive control in the ABTS assay, with results expressed as milligrams of Trolox equivalent antioxidant capacity (TEAC) per gram of extract (mg TEAC/g).
Overall, the results from all three assays were expressed in terms of milligram Trolox equivalent antioxidant capacity (TEAC) per gram of extract (mg TEAC/g extract), allowing for a standardized comparison of antioxidant capacity across different extracts.
2.7 RP-HPLC-ESI-MS Analysis of Extracts
The reverse-phase high-performance liquid chromatography (RP-HPLC) analysis in this study was performed following the method of Paz-Arteaga et al. [34]. A Varian ProStar 410 HPLC system (USA) equipped with an autosampler, ternary pump, and photodiode array detector was used. Additionally, a liquid chromatography ion-trap mass spectrometer (MS) with an electrospray ionization source was employed to enhance detection sensitivity and compound identification. Samples (5 µL) were injected into a C18 column, with the column temperature maintained at 30°C. The elution solvents used were formic acid and acetonitrile, and a gradient program was implemented, increasing acetonitrile concentration from 3% to 50% throughout the analysis. Detection occurred at multiple wavelengths, while all mass spectrometry experiments were conducted in negative ionization mode, with nitrogen as the nebulizing gas and helium as the damping gas.
The ion source parameters included a spray voltage of 5.0 kV, a capillary voltage of 90.0 V, and a temperature of 350°C. Data collection and processing were carried out using MS Workstation software (Version 6.9), employing full scan mode across a mass-to-charge ratio (m/z) range of 50–2000. Phenolic compounds were identified by comparing HPLC retention times with mass spectrometry data, and their molecular weights were verified through cross-referencing literature and a database maintained by the Food Research Department at the Autonomous University of Coahuila (DIA-UAdeC).
2.8 Experimental Design and Statistical Analysis
Experiments were conducted at three different levels of measurement, which included various cultivars and locations. The results were reported as mean values along with their standard deviations (SD). Statistical analysis was performed using one-way analysis of variance (ANOVA), with the independent variable being the combination of cultivar and location. For post-hoc analysis, Tukey’s Honestly Significant Difference (HSD) test was applied, using a significance level (α) of 0.05. Data analysis was carried out using IBM SPSS Statistics software (SPSS).
3.1 Extraction of Polyphenolic Bioactive Compounds
This study demonstrated the extraction of bioactive compounds from the leaves and stems of L. tridentata using UAE with various solvent mixtures. The colour of the leaf extracts ranged from dark brown to light green, while stem extracts varied from light brown to yellow. The highest yield was achieved with 60% ethanol for the leaf extract, yielding 12.5%, whereas a 50% ethanol solution yielded 8.35% (Table 1). Aqueous extracts provided the lowest yields for both leaves and stems of L. tridentata. The yield reported by Skouta et al. [35] which utilized 60% ethanol, was higher than observed in this study; this discrepancy can be attributed to the mass-to-volume ratio used (16 g by Skouta et al. [35] vs. 5 g in this study), which influences yield of the extract. The yield of the maceration leaf extract reported by Skouta et al. [35] was lower than that obtained through UAE in this study, highlighting the superior efficiency of UAE for extracting compounds from L. tridentata.

Moreover, the yield of the extracts was positively correlated with the increasing polarity of the solvent mixtures, indicating that higher polarity solvents enhance the extraction efficiency [36]. UAE employs high-frequency sound waves to extract compounds from plant tissues. During the rarefaction phase, negative pressure forms cavitation bubbles that absorb ultrasound energy. In the compression phase, these bubbles collapse rapidly, generating high temperatures and pressures that disrupt plant cell structures and release bioactive compounds into the extraction medium [7].
Ultrasound assisted L. tridentata leaves extracts aqueous (ULL aq), Ultrasound assisted L. tridentata leaves extracts 50% ethanol (ULL 50%), Ultrasound assisted L. tridentata leaves extracts 60% ethanol (ULL 60%), Ultrasound assisted L. tridentata leaves extracts 100% ethanol (ULL 100%), Ultrasound assisted L. tridentata stems extract aqueous (ULS aq), Ultrasound assisted L. tridentata stems extract 50% ethanol (ULS 50%), Ultrasound assisted L. tridentata stems extract 60% ethanol (ULS 60%), Ultrasound assisted L. tridentata stems extract 100% ethanol (ULS 100%).
Polyphenol, a class of secondary metabolites, are widely distributed across plants organs such as leaves bark, roots, and stems [37,38]. These compounds are categorized into two main types based on their structure: hydrolysable tannins (HT), and condensed tannins (CT). Hydrolysable tannins consist of gallic acids and ellagic acid derivatives, linked through ester or ether bonds. Upon hydrolysis, they release free phenolic acids, contributing to their notable antibacterial and antifungal properties, which have been traditionally exploited in folk medicine.
CT, also known as proanthocyanidins are composed of flavonoid units like catechins and epicatechins. These tannins, commonly found in fruits, berries, and leaves, are further classified into oligomeric and polymeric proanthocyanidins based on their degree of polymerization. They exhibit various biological activities, including antioxidant, anti-inflammatory, and cardioprotective effects.
The tannins (HT and CT) content in the leaves and stems increased proportionally with the concentration of ethanol in the mixture [39], as illustrated in (Fig. 1a,b). Among the various concentrations tested, leaf extract (60%) demonstrated the highest levels of both HT (690.2 mg GAE/100 g DW) and CT (329.9 mg CE/100 g DW), whereas the aqueous stem extract exhibited the lowest polyphenol content (115.8 mg GAE/100 g DW and 114.5 mg CE/100 g DW) for the HT and CT, respectively.

Figure 1: Hydrolysable tannins (a) and condensed tannins (b) composition of leaf and stem extracts. Ultrasound assisted L. tridentata leaves extracts aqueous (ULL aq), Ultrasound assisted L. tridentata leaves extracts 50% ethanol (ULL 50%), Ultrasound assisted L. tridentata leaves extracts 60% ethanol (ULL 60%), Ultrasound assisted L. tridentata leaves extracts 100% ethanol (ULL 100%), Ultrasound assisted L. tridentata stems extract aqueous (ULS aq), Ultrasound assisted L. tridentata stems extract 50% ethanol (ULS 50%), Ultrasound assisted L. tridentata stems extract 60% ethanol (ULS 60%), Ultrasound assisted L. tridentata stems extract 100% ethanol (ULS 100%)
Authors [40] found that the phenolic content in L. tridentata extracted via maceration and UAE was lower than that reported in this study. This discrepancy may result from differences in solvent concentration, extraction methods, and the timing of plant collection, which can significantly impact the yield of phenolic compounds.
The increase in the polyphenol content as the ratio of ethanol to water increased can be attributed to the pronounced polarity of the polyphenolic compounds in the samples [41]. The polyphenolic content decreased in absolute ethanol. This decline can be associated with the volatility of the solvent during the absorption of energy from ultrasound waves in the compression phase, which results in an increase in the temperature of the solvent molecules during the extraction process [42]. The leaves of L. tridentata were found to contain a higher abundance of hydrolysable polyphenols than the stems [40]. In contrast, the stems contained more condensed polyphenols than the leaves. This suggests that the plant possesses a higher concentration of hydrolysable polyphenolic compounds, which may contribute to their medicinal and antioxidant benefits [43].
Analysis of L. tridentata leaves and stems from UAE using RP-HPLC-ESI-MS identified 21 polyphenolic compounds including quercetin, luteolin, 3,4-DHPEA, elenolic acid, NDGA, kaempferide, caffeic acid 4-O-glucoside, 5-heptadecylresorcinol, rhamnetin, 3,7-dimethylquercetin, protocatechuic acid 4-O-glucoside, methylgalangin, glycitein, and pterostilbene (Table 2).

These polyphenols are known for their diverse biological activities, particularly their antifungal properties, which contribute to the control of fungal diseases. Among the extracts, 60% ethanol extracts from leaves (ULL) showed the highest polyphenol content, whereas aqueous extracts had the lowest content. Stem extracts (ULS) with 50% ethanol contained higher levels of condensed tannins than their leaf counterparts (Fig. 1).
Liu et al. [23] demonstrated that polyphenols inhibit fungal growth by interacting with fungal proteins and cell wall components, leading to structural and functional damage.
In agricultural practices, plant-derived polyphenols offer a sustainable alternative to synthetic chemicals for crop protection [44].
Ayoub et al. [45] investigated the potential therapeutic use of polyphenols for treating fungal diseases in plants by examining the efficacy of polyphenol-rich plant extracts and isolated compounds as complementary or alternative antifungal agents.
Flavonoids, such as quercetin (1), luteolin (2), 3,4-DHPEA (3), elenolic acid (4), NDGA (5), and kaempferide (6) (Fig. 2), found in the extracts have been reported to interfere with fungal cell membranes, disrupt enzymatic processes, and induce oxidative stress, ultimately inhibiting fungal growth and viability [46–48].

Figure 2: Bioactive compounds identified from L. tridentata
Fernández-Calderón et al. [49] reported the presence of 3,4-DHPEA and elenolic acid as phytoconstituents in olive oil and they are implicated for the antifungal properties of the oil. Luteolin, a flavonoid, has significant antifungal properties against various microorganisms, particularly against F. oxysporum and A. alternata.
Elenolic acid, particularly its dialdehydic form, linked to hydroxytyrosol or tyrosol, exhibits significant antimicrobial properties [50].
NDGA, the main metabolite of the creosote bush, exhibits promising antifungal activity and has potential applications in the treatment of various diseases [51,52].
Chandrakala et al. [53] reported that NDGA may interfere with essential cellular processes or inhibit enzymes crucial for fungal growth.
Ultrasound assisted L. tridentata leaves extracts aqueous (ULL aq), Ultrasound assisted L. tridentata leaves extracts 50% ethanol (ULL 50%), Ultrasound assisted L. tridentata leaves extracts 60% ethanol (ULL 60%), Ultrasound assisted L. tridentata leaves extracts 100% ethanol (ULL 100%), Ultrasound assisted L. tridentata stems extract aqueous (ULS aq), Ultrasound assisted L. tridentata stems extract 50% ethanol (ULS 50%), Ultrasound assisted L. tridentata stems extract 60% ethanol (ULS 60%), Ultrasound assisted L. tridentata stems extract 100% ethanol (ULS 100%).
3.3 Antifungal Activities of L. tridentata Leaves and Stems UAE Extracts
These results indicate that the L. tridentata extract produces active substances, specifically polyphenols, that inhibit the growth of A. alternata and F. oxysporum.
For example, the 50% ethanol extract from the leaves (ULL) significantly inhibited the growth of A. alternata by 53.61%, whereas the 100% ethanol extract exhibited the highest inhibition against F. oxysporum, achieving a rate of 60.03% (Table 3 and Fig. 3).

Figure 3: Ultrasound assisted L. tridentata leaves extracts 50% ethanol (ULL 50%), Ultrasound assisted L. tridentata leaves extracts 60% ethanol (ULL 60%), Ultrasound assisted L. tridentata leaves extracts 100% ethanol (ULL 100%), Ultrasound assisted L. tridentata stems extract aqueous (ULS aq), Controls, F. oxysporum (FO) and A. alternata (AA). (Note: Subscale of 2 cm × 2 cm in each subfigure)
Antifungal activity was correlated with the relative polyphenol content of the extracts. In contrast, aqueous stem extracts showed minimal inhibition against both A. alternata and F. oxysporum.
Tucuch-Perez et al. [54] reported similar findings, noting that aqueous stem extracts of Lippia graveolens, Agave lechuguilla, and Carya illinoinensis also exhibited low inhibitory effects on these fungi.
Furthermore, Salas-Gómez et al. [55] found 52.32% inhibition of F. oxysporum and 24% inhibition of A. alternata with extracts from mistletoe grown on oak and mesquite, respectively. Notably, in this study, improved inhibition was observed at lower concentrations of the extract (5%). Additionally, the stem extracts of L. tridentata exhibited lower antifungal activity than the leaf extracts did. This disparity may be attributed to the higher total phenolic content in the leaf extracts, which contributed to their enhanced antifungal properties.
Ultrasound assisted L. tridentata leaves extracts aqueous (ULL aq), Ultrasound assisted L. tridentata leaves extracts 50% ethanol (ULL 50%), Ultrasound assisted L. tridentata leaves extracts 60% ethanol (ULL 60%), Ultrasound assisted L. tridentata leaves extracts 100% ethanol (ULL 100%), Ultrasound assisted L. tridentata stems extract aqueous (ULS aq), Ultrasound assisted L. tridentata stems extract 50% ethanol (ULS 50%), Ultrasound assisted L. tridentata stems extract 60% ethanol (ULS 60%), Ultrasound assisted L. tridentata stems extract 100% ethanol (ULS 100%).
Ultrasound assisted L. tridentata leaves extracts aqueous (ULL aq), Ultrasound assisted L. tridentata leaves extracts 50% (ULL 50%), Ultrasound assisted L. tridentata leaves extracts 60% (ULL 60%), Ultrasound assisted L. tridentata leaves extracts 100% (ULL 100%), Ultrasound assisted L. tridentata stems extract aqueous (ULS aq), Ultrasound assisted L. tridentata stems extract 50% (ULS 50%), Ultrasound assisted L. tridentata stems extract 60% (ULS 60%), Ultrasound assisted L. tridentata stems extract 100% (ULS 100%).
3.3.1 Antioxidant Activities of the Extracts
The antioxidant activity of L. tridentata was evaluated using the DPPH method, which revealed a range of 153.2 to 265.2 mg TEAC/g DW (leaves) and 112.2 to 196.7 mg TEAC/g DW (stems) (Table 4). The results showed that the extracts were able to scavenge radicals, these involves neutralizing reactive oxygen species and preventing oxidative damage.

This can be attributed to the phenolic compounds present in plant extracts as known for their radical-scavenging mechanisms. They can directly interact with and neutralize free radicals, offering protection against oxidative stress. The relative antioxidant ability was compared with that of the standard Trolox using the ABTS+ assay, which produces a stable radical cation with potassium persulfate. Antioxidant power was measured by studying the decolorization of the reaction medium. The TEAC values ranged from 43.2 to 60.0 mg TEAC/g DW (leaves) and 6.9 to 36.8 mg TEAC/g DW (stems). The lowest values were observed for the aqueous extracts of leaves and stems (43.2 and 6.9 mg TEAC/g dw, respectively), while the highest values were observed for the 100% ethanol and 60% ethanol extracts of leaves and stems (60.0 and 36.8 mg TEAC/g DW, respectively).
Notably, the TEAC values obtained using the ABTS assay were lower than those obtained using the DPPH assay. The ABTS assay is a more complex reaction mechanism than the DPPH assay, as it generates a radical cation through hydrogen peroxide and an oxidizing agent, while the DPPH assay is simpler and more direct. The ABTS assay have higher sensitivity due to faster reaction kinetics, while the DPPH assay has limitations like poor sensitivity and slower reaction kinetics. Structural preferences in compounds can also influence the results, as phenolic acids may show different trends in antioxidant activity [56].
The FRAP assay measures the reducing potential of an antioxidant that reacts with ferric tripyridyltriazine (Fe3+ -TPTZ) complex to produce coloured ferrous tripyridyltriazine (Fe2+ -TPTZ). The process of free-radical chain initiation involves the transfer of a hydrogen atom. At a pH of approximately 3.6, the Fe3+ -TPTZ complex was reduced to blue-coloured Fe2+ -TPTZ, which exhibited absorbance at 593 nm. The FRAP values for the examined plants ranged from 101.0 to 122.1 (leaves) and 89.5 to 113.2 (stems) per Trolox equivalent per gram of dry weight for L. tridentata.
Phenolic compounds, secondary metabolites found in plants such as quercetin (1), luteolin (2), 3,4-DHPEA (3), elenolic acid (4), NDGA (5), and kaempferide (6), contribute to the antioxidant capacity of plant extracts by neutralizing free radicals and providing protection against oxidative stress. Muflihah et al. [57] have shown a direct relationship between antioxidant activity and the presence of phenolic compounds, with the total phenolic content in wines strongly correlated with antioxidant activity. Phenolic compounds, such as quercetin, luteolin, Glycitein, Kaempferide, and NDGA, have been found to have antibacterial and antifungal properties. Quercetin, known for its antioxidant properties, has been shown to combat various pathogens. Luteolin, a flavonoid, has been found to inhibit pathogenic microorganism growth. Glycitein, a soy isoflavone, has been identified for its antimicrobial properties. Kaempferide, a flavonol, has antimicrobial potential and is effective against bacteria and fungi. NDGA, extracted from plants like creosote bush, has strong antibacterial and antifungal activities. The antifungal activity of phenolic compounds involves complex biochemical interactions that can inhibit fungal growth and development.
The experimental outcomes were highly consistent and linearly proportional to the molar concentration of the antioxidants. This finding aligns with those reported by [58,59].
UAE offers a faster, more efficient, and environmentally friendly method of extracting bioactive compounds, notably reducing time and solvent consumption, making it ideal for recovering polyphenols. Extracts from L. tridentata leaves and stems showed strong antioxidant activity in vitro, confirmed through ABTS, DPPH, and FRAP assays. Major polyphenolic compounds identified via HPLC-MS, including quercetin, luteolin, elenolic acid, NDGA, and kaempferide, are believed to interact with cell membranes, potentially disrupting the lipid bilayer and affecting cellular functions such as ATP synthesis. While this interaction could lead to cell death, further mechanistic studies are necessary to confirm this hypothesis.
Moreover, the extracts demonstrated fungistatic effects against F. oxysporum and A. alternata, though further quantitative analysis is required to determine the extent of inhibition.
Future research should focus on in vivo validation and the encapsulation of these compounds into biocontrol formulations. Encapsulation could enhance the stability and efficacy of these bioactives, providing prolonged protection against pathogens in agricultural applications.
This study reinforces the growing body of evidence supporting the use of L. tridentata as a natural, sustainable alternative for postharvest disease management in agriculture.
Acknowledgement: Muyideen Olaitan Bamidele appreciated National Council of Humanities, Sciences and Technologies (CONACYT, Mexico) for PhD fellowship support awarded to me (1245491).
Funding Statement: This work was supported by the appreciated National Council of Humanities, Sciences and Technologies (CONAHCYT, Mexico), through the PhD fellowship grant (No. 1245491) awarded to Muyideen Olaitan Bamidele.
Author Contributions: Funding acquisition, Methodology, Investigation, Conceptualization, Writing—review & editing: Muyideen Olaitan Bamidele; Writing—original draft, Writing—review & editing, Supervision, Validation: José Sandoval-Cortés; Investigation, Formal analysis, Supervision, Writing—original draft, Writing—review & editing: María Liliana Flores-López; Investigation, Supervision, Writing—review & editing, Writing—original draft: Olga Berenice Álvarez Pérez; Supervision, Resources, Writing—original draft, Writing—review & editing, Investigation: Monica Lizeth Chavez González; Writing—review & editing, Writing—original draft, Project administration, Formal analysis, Supervision, Data curation: Cristóbal Noe Aguilar. All authors reviewed the results and approved the final version of the manuscript.
Availability of Data and Materials: The datasets used and/or analysed during the current study are available from the author and/or corresponding author on reasonable request.
Ethics Approval: Not applicable.
Conflicts of Interest: The authors declare no conflicts of interest to report regarding the present study.
References
1. Jurick WM, Adaskaveg JE. Postharvest diseases. In: Agrios’ plant pathology. Elsevier; 2024. p. 317–30. doi:10.1016/B978-0-12-822429-8.00011-X. [Google Scholar] [CrossRef]
2. Urugo MM, Yohannis E, Teka TA, Gemede HF, Tola YB, Forsido SF. Addressing post-harvest losses through agro-processing for sustainable development in Ethiopia. J Agric Food Res. 2024;18:101316. doi:10.1016/j.jafr.2024.101316. [Google Scholar] [CrossRef]
3. Bhattacharya R, Bose D, Gulia K, Jaiswal A. Impact of antimicrobial resistance on sustainable development goals and the integrated strategies for meeting environmental and socio-economic targets. Environ Prog Sustain Energy. 2024;43. doi:10.1002/ep.14320. [Google Scholar] [CrossRef]
4. Torres-Palazzolo C, Ferreyra S, Hugalde IP, Kuhn Y, Combina M, Ponsone ML. Recent advances in biocontrol and other alternative strategies for the management of postharvest decay in table grapes. Int J Food Microbiol. 2024;420:110766. doi:10.1016/j.ijfoodmicro.2024.110766 [Google Scholar] [PubMed] [CrossRef]
5. Mohd Zainudin NAI, Abd Murad NB, Shaari FN. Utilisation of plant-based product in post-harvest disease management of fruits. In: Advances in tropical crop protection. Cham: Springer Nature Switzerland; 2024. p. 121–55. doi: 10.1007/978-3-031-59268-3_9. [Google Scholar] [CrossRef]
6. Wen L, Zhang Z, Sun D-W, Sivagnanam SP, Tiwari BK. Combination of emerging technologies for the extraction of bioactive compounds. Crit Rev Food Sci Nutr. 2020;60:1826–41. doi:10.1080/10408398.2019.1602823 [Google Scholar] [PubMed] [CrossRef]
7. Shen L, Pang S, Zhong M, Sun Y, Qayum A, Liu Y. A comprehensive review of ultrasonic assisted extraction (UAE) for bioactive components: principles, advantages, equipment, and combined technologies. Ultrason Sonochem. 2023;101:106646. doi:10.1016/j.ultsonch.2023.106646 [Google Scholar] [PubMed] [CrossRef]
8. da Silva RF, Carneiro CN, de Sousa CBDC, Gomez JVF, Espino M, Boiteux J. Sustainable extraction bioactive compounds procedures in medicinal plants based on the principles of green analytical chemistry: a review. Microchem J. 2022;175:107184. doi:10.1016/j.microc.2022.107184. [Google Scholar] [CrossRef]
9. Yu L, Zhou Y, Chen Y, Wang Y, Gu Q, Song D. Antifungal activity and mechanism of Litsea cubeba (Lour.) Persoon essential oil against the waxberry spoilage fungi Penicillium oxalicum and its potential application. Int J Food Microbiol. 2024;411:110512. doi:10.1016/j.ijfoodmicro.2023.110512 [Google Scholar] [PubMed] [CrossRef]
10. Sasidharan S, Shanmugapriya, Jothy SL, Vijayarathna S, Kavitha N, Oon CE. Conventional and non-conventional approach towards the extraction of bioorganic phase. In: Bioorganic phase in natural food: an overview. Cham: Springer International Publishing; 2018. p. 41–57. doi: 10.1007/978-3-319-74210-6_4. [Google Scholar] [CrossRef]
11. Cheng Y, Zhao H, Cui L, Hussain H, Nadolnik L, Zhang Z. Ultrasonic-assisted extraction of flavonoids from peanut leave and stem using deep eutectic solvents and its molecular mechanism. Food Chem. 2024;434:137497. doi:10.1016/j.foodchem.2023.137497 [Google Scholar] [PubMed] [CrossRef]
12. Oubannin S, Bijla L, Ahmed MN, Ibourki M, El Kharrassi Y, Devkota K. Recent advances in the extraction of bioactive compounds from plant matrices and their use as potential antioxidants for vegetable oils enrichment. J Food Compost Anal. 2024;128:105995. doi:10.1016/j.jfca.2024.105995. [Google Scholar] [CrossRef]
13. Goswami MJ, Dutta U, Kakati D. Ultrasound-assisted extraction for food, pharmacy, and biotech industries. In: Sarkar T, Pati S, editors. Bioactive extraction and application in food and nutraceutical industries. Humana, New York, NY: Methods and Protocols in Food Science; 2024. p. 103–28. doi:10.1007/978-1-0716-3601-5_5. [Google Scholar] [CrossRef]
14. Irakli M, Skendi A, Bouloumpasi E, Christaki S, Biliaderis CG, Chatzopoulou P. Sustainable recovery of phenolic compounds from distilled rosemary by-product using green extraction methods: optimization, comparison, and antioxidant activity. Molecules. 2023;28:6669. doi:10.3390/molecules28186669 [Google Scholar] [PubMed] [CrossRef]
15. Martins R, Barbosa A, Advinha B, Sales H, Pontes R, Nunes J. Green extraction techniques of bioactive compounds: a state-of-the-art review. Processes. 2023;11:2255. doi:10.3390/pr11082255. [Google Scholar] [CrossRef]
16. Zhu J, Kou X, Wu C, Fan G, Li T, Dou J. Enhanced extraction of bioactive natural products using ultrasound-assisted aqueous two-phase system: application to flavonoids extraction from jujube peels. Food Chem. 2022;395:133530. doi:10.1016/j.foodchem.2022.133530 [Google Scholar] [PubMed] [CrossRef]
17. Khursheed T, Khalil AA, Akhtar MN, Khalid A, Tariq MR, Alsulami T. Ultrasound-assisted solvent extraction of phenolics, flavonoids, and major triterpenoids from Centella asiatica leaves: a comparative study. Ultrason Sonochem. 2024;111:107091. doi:10.1016/j.ultsonch.2024.107091 [Google Scholar] [PubMed] [CrossRef]
18. Keskin Çavdar H, Avşar S. Ultrasonic extraction of Inula viscosa: enhancing antioxidant bioactivity and its application in sunflower oil as an antioxidant. Ultrason Sonochem. 2024;109:106992. doi:10.1016/j.ultsonch.2024.106992 [Google Scholar] [PubMed] [CrossRef]
19. Chen Z, Wang C, Su J, Liang G, Tan S, Bi Y. Extraction of Pithecellobium clypearia Benth polysaccharides by dual-frequency ultrasound-assisted extraction: structural characterization, antioxidant, hypoglycemic and anti-hyperlipidemic activities. Ultrason Sonochem. 2024;107:106918. doi:10.1016/j.ultsonch.2024.106918 [Google Scholar] [PubMed] [CrossRef]
20. Gautam AK, Singh PK, Aravind M. Defensive role of plant phenolics against pathogenic microbes for sustainable agriculture. In: Plant phenolics in sustainable agriculture. Singapore: Springer Singapore; 2020. p. 579–94. doi: 10.1007/978-981-15-4890-1_25. [Google Scholar] [CrossRef]
21. Morales-Ubaldo AL, Rivero-Perez N, Avila-Ramos F, Aquino-Torres E, Prieto-Méndez J, Hetta HF. Bactericidal activity of Larrea tridentata hydroalcoholic extract against phytopathogenic bacteria. Agronomy. 2021;11. doi:10.3390/agronomy11050957. [Google Scholar] [CrossRef]
22. Mandal MK, Domb AJ. Antimicrobial activities of natural bioactive polyphenols. Pharmaceutics. 2024;16:718. doi:10.3390/pharmaceutics16060718 [Google Scholar] [PubMed] [CrossRef]
23. Liu X, Wei L, Miao C, Zhang Q, Yan J, Li S. Application of exogenous phenolic compounds in improving postharvest fruits quality: classification, potential biochemical mechanisms and synergistic treatment. Food Rev Int. 2024;40:1776–95. doi:10.1080/87559129.2023.2233599. [Google Scholar] [CrossRef]
24. Petcu CD, Tăpăloagă D, Mihai OD, Gheorghe-Irimia R-A, Negoiţă C, Georgescu IM, et al. Harnessing natural antioxidants for enhancing food shelf life: exploring sources and applications in the food industry. Foods. 2023;12:3176. doi:10.3390/foods12173176 [Google Scholar] [PubMed] [CrossRef]
25. Nxumalo KA, Aremu AO, Fawole OA. Metabolite profiling, antioxidant, and antibacterial properties of four medicinal plants from Eswatini and their relevance in food preservation. S Afr J Bot. 2023;162:719–29. doi:10.1016/j.sajb.2023.10.008. [Google Scholar] [CrossRef]
26. Núñez-Mojica G, Vázquez-Ramírez AL, García A, Rivas-Galindo VM, Garza-González E, Cuevas González-Bravo GE. New cyclolignans of Larrea tridentata and their antibacterial and cytotoxic activities. Phytochem Lett. 2021;43:212–8. doi:10.1016/j.phytol.2021.04.013. [Google Scholar] [CrossRef]
27. Garcia-Vaquero M. Green extraction of bioactive compounds from microalgae and seaweeds. In: Functional ingredients from algae for foods and nutraceuticals. Elsevier; 2023. p. 115–47. doi:10.1016/B978-0-323-98819-3.00013-4. [Google Scholar] [CrossRef]
28. George J, Edwards D, Pun S, Williams D. Evaluation of antioxidant capacity (ABTS and CUPRAC) and total phenolic content (Folin-Ciocalteu) assays of selected fruit, vegetables, and spices. Int J Food Sci. 2022;2022:1–18. doi:10.1155/2022/2581470 [Google Scholar] [PubMed] [CrossRef]
29. Bautista-Hernández I, Aguilar CN, Martínez-Ávila GCG, Ilina A, Torres-León C, Verma DK. Phenolic compounds and antioxidant activity of Lippia graveolens Kunth residual leaves fermented by two filamentous fungal strains in solid-state process. Food Bioprod Process. 2022;136:24–35. doi:10.1016/j.fbp.2022.09.001. [Google Scholar] [CrossRef]
30. Osman Mohamed Ali E, Shakil NA, Rana VS, Sarkar DJ, Majumder S, Kaushik P. Antifungal activity of nano emulsions of neem and citronella oils against phytopathogenic fungi, Rhizoctonia solani and Sclerotium rolfsii. Ind Crops Prod. 2017;108:379–87. doi:10.1016/j.indcrop.2017.06.061. [Google Scholar] [CrossRef]
31. Castro-López C, Bautista-Hernández I, González-Hernández MD, Martínez-Ávila GCG, Rojas R, Gutiérrez-Díez A. Polyphenolic profile and antioxidant activity of leaf purified hydroalcoholic extracts from seven mexican Persea americana cultivars. Molecules. 2019;24:173. doi:10.3390/molecules24010173 [Google Scholar] [PubMed] [CrossRef]
32. Kim J-S. Antioxidant activity of various soluble melanoidins isolated from black garlic after different thermal processing steps. Prev Nutr Food Sci. 2020;25:301–9. doi:10.3746/pnf.2020.25.3.301 [Google Scholar] [PubMed] [CrossRef]
33. Bautista-Hernández I, Gómez-García R, Aguilar CN, Martínez-Ávila GCG, Torres-León C, Chávez-González ML. Solid-state fermentation for phenolic compounds recovery from mexican oregano (Lippia graveolens Kunth) residual leaves applying a lactic acid bacteria (Leuconostoc mesenteroides). Agriculture. 2024;14:1342. doi:10.3390/agriculture14081342. [Google Scholar] [CrossRef]
34. Paz-Arteaga SL, Ascacio-Valdés JA, Aguilar CN, Cadena-Chamorro E, Serna-Cock L, Aguilar-González MA. Bioprocessing of pineapple waste for sustainable production of bioactive compounds using solid-state fermentation. Innov Food Sci Emerg Technol. 2023;85:103313. doi:10.1016/j.ifset.2023.103313. [Google Scholar] [CrossRef]
35. Skouta R, Morán-Santibañez K, Valenzuela CA, Vasquez AH, Fenelon K. Assessing the antioxidant properties of Larrea tridentata extract as a potential molecular therapy against oxidative stress. Molecules. 2018;23. doi:10.3390/molecules23071826 [Google Scholar] [PubMed] [CrossRef]
36. González-Cardoso MA, Cerón-García MC, Navarro-López E, Molina-Miras A, Sánchez-Mirón A, Contreras-Gómez A. Alternatives to classic solvents for the isolation of bioactive compounds from Chrysochromulina rotalis. Bioresour Technol. 2023;379:129057. doi:10.1016/j.biortech.2023.129057 [Google Scholar] [PubMed] [CrossRef]
37. Ahlawat YK, Singh M, Manorama K, Lakra N, Zaid A, Zulfiqar F. Plant phenolics: neglected secondary metabolites in plant stress tolerance. Braz J Bot. 2023. doi:10.1007/s40415-023-00949-x. [Google Scholar] [CrossRef]
38. Bhatla SC, Lal MA. Secondary metabolites. In: Plant physiology, development and metabolism. Singapore: Springer Nature Singapore; 2023. p. 765–808. doi: 10.1007/978-981-99-5736-1_33. [Google Scholar] [CrossRef]
39. Audah KA, Ettin J, Darmadi J, Azizah NN, Anisa AS, Hermawan TDF. Indonesian mangrove Sonneratia caseolaris leaves ethanol extract is a potential super antioxidant and anti methicillin-resistant staphylococcus aureus drug. Molecules. 2022;27:8369. doi:10.3390/molecules27238369 [Google Scholar] [PubMed] [CrossRef]
40. Palma-Wong M, Ascacio-Valdés JA, Ramírez-Guzmán N, Aguirre-Joya JA, Flores-Loyola E, Ramírez-Moreno A. Exploration of phenolic content and antioxidant potential from plants used in traditional medicine in viesca. Viesca, Mexico. Horticulturae. 2023;9:1252. doi:10.3390/horticulturae9121252. [Google Scholar] [CrossRef]
41. Lima RC, de Carvalho APA, da Silva BD, Torres Neto L, de Figueiredo MRDS, Chaves PHT, et al. Green ultrasound-assisted extraction of bioactive compounds of babassu (Attalea speciosa) mesocarp: effects of solid-liquid ratio extraction, antioxidant capacity, and antimicrobial activity. Appl Food Res. 2023;3. doi:10.1016/j.afres.2023.100331. [Google Scholar] [CrossRef]
42. Aguilar-Veloz LM, Calderón-Santoyo M, Vázquez González Y, Ragazzo-Sánchez JA. Application of essential oils and polyphenols as natural antimicrobial agents in postharvest treatments: advances and challenges. Food Sci Nutr. 2020;8:2555–68. doi:10.1002/fsn3.1437 [Google Scholar] [PubMed] [CrossRef]
43. Carlos E, Martins R, Fortunato E, Branquinho R. Solution combustion synthesis: towards a sustainable approach for metal oxides. Chem A Eur J. 2020;26:9099–125. doi:10.1002/chem.202000678 [Google Scholar] [PubMed] [CrossRef]
44. Chowdhury NN, Islam MN, Jafrin R, Rauf A, Khalil AA, Emran TB, et al. Natural plant products as effective alternatives to synthetic chemicals for postharvest fruit storage management. Crit Rev Food Sci Nutr. 2023;63:10332–50. doi:10.1080/10408398.2022.2079112 [Google Scholar] [PubMed] [CrossRef]
45. Ayoub WS, Ritu, Zahoor I, Dar AH, Farooq S, Mir TA. Exploiting the polyphenolic potential of honey in the prevention of chronic diseases. Food Chem Adv. 2023;3(11):100373. doi:10.1016/j.focha.2023.100373. [Google Scholar] [CrossRef]
46. Kim J-H, Lee J, Jeong H, Bang MS, Jeong J-H, Chang M. Nordihydroguaiaretic acid as a novel substrate and inhibitor of catechol O-methyltransferase modulates 4-hydroxyestradiol-induced cyto- and genotoxicity in MCF-7 cells. Molecules. 2021;26:2060. doi:10.3390/molecules26072060 [Google Scholar] [PubMed] [CrossRef]
47. Chen K-C, Hsu W-H, Ho J-Y, Lin C-W, Chu C-Y, Kandaswami CC. Flavonoids Luteolin and Quercetin Inhibit RPS19 and contributes to metastasis of cancer cells through c-Myc reduction. J Food Drug Anal. 2018;26:1180–91. doi:10.1016/j.jfda.2018.01.012 [Google Scholar] [PubMed] [CrossRef]
48. Fan J-J, Hsu W-H, Lee K-H, Chen K-C, Lin C-W, Lee Y-L. Dietary flavonoids luteolin and quercetin inhibit migration and invasion of squamous carcinoma through reduction of Src/Stat3/S100A7 signaling. Antioxidants. 2019;8:557. doi:10.3390/antiox8110557 [Google Scholar] [PubMed] [CrossRef]
49. Fernández-Calderón MC, Navarro-Pérez ML, Blanco-Roca MT, Gómez-Navia C, Pérez-Giraldo C, Vadillo-Rodríguez V. Chemical profile and antibacterial activity of a novel Spanish propolis with new polyphenols also found in olive oil and high amounts of flavonoids. Molecules. 2020;25:3318. doi:10.3390/molecules25153318 [Google Scholar] [PubMed] [CrossRef]
50. Thielmann J, Kohnen S, Hauser C. Antimicrobial activity of Olea europaea Linné extracts and their applicability as natural food preservative agents. Int J Food Microbiol. 2017;251:48–66. doi:10.1016/j.ijfoodmicro.2017.03.019 [Google Scholar] [PubMed] [CrossRef]
51. Kimura K, Chun JH, Lin Y-L, Liang Y-C, Jackson TLB, Huang RCC. Tetra-O-methyl-nordihydroguaiaretic acid inhibits energy metabolism and synergistically induces anticancer effects with temozolomide on LN229 glioblastoma tumors implanted in mice while preventing obesity in normal mice that consume high-fat diets. PLoS One. 2023;18:e0285536. doi:10.1371/journal.pone.0285536 [Google Scholar] [PubMed] [CrossRef]
52. Villalobos-Sánchez E, García-Ruiz D, Camacho-Villegas TA, Canales-Aguirre AA, Gutiérrez-Ortega A, Muñoz-Medina JE. In vitro antiviral activity of nordihydroguaiaretic acid against SARS-CoV-2. Viruses. 2023;15:1155. doi:10.3390/v15051155 [Google Scholar] [PubMed] [CrossRef]
53. Chandrakala V, Aruna V, Angajala G, Reddy PG. Chemical composition and pharmacological activities of essential oils. In: Essential oils. Wiley; 2023. p. 229–68. doi: 10.1002/9781119829614.ch11. [Google Scholar] [CrossRef]
54. Tucuch-Perez MA, Arredondo-Valdes R, Hernandez-Castillo FD. Antifungal activity of phytochemical compounds of extracts from Mexican semi-desert plants against Fusarium oxysporum from tomato by microdilution in plate method. Nova Sci. 2020;12(25). doi:10.21640/ns.v12i25.2345. [Google Scholar] [CrossRef]
55. Salas-Gómez AL, Espinoza Ahumada CA, Castillo Godina RG, Ascacio-Valdés JA, Rodríguez-Herrera R, de Jesus Segura Martínez MT, et al. Antifungal in vitro activity of Phoradendron sp. extracts on fungal isolates from tomato crop. Plants. 2023;12:672. doi:10.3390/plants12030672 [Google Scholar] [PubMed] [CrossRef]
56. Wang Y, Li C, Li Z, Moalin M, den Hartog GJM, Zhang M. Computational chemistry strategies to investigate the antioxidant activity of flavonoids—An overview. Molecules. 2024;29:2627. doi:10.3390/molecules29112627 [Google Scholar] [PubMed] [CrossRef]
57. Muflihah YM, Gollavelli G, Ling Y-C. Correlation study of antioxidant activity with phenolic and flavonoid compounds in 12 indonesian indigenous herbs. Antioxidants. 2021;10:1530. doi:10.3390/antiox10101530 [Google Scholar] [PubMed] [CrossRef]
58. Zhou X, Gong X, Li X, An N, He J, Zhou X. The antioxidant activities in vitro and in vivo and extraction conditions optimization of defatted walnut kernel extract. Foods. 2023;12:3417. doi:10.3390/foods12183417 [Google Scholar] [PubMed] [CrossRef]
59. Aguirre-Joya JA, Pastrana-Castro L, Nieto-Oropeza D, Ventura-Sobrevilla J, Rojas-Molina R, Aguilar CN. The physicochemical, antifungal and antioxidant properties of a mixed polyphenol based bioactive films. Heliyon. 2018;4:942. doi:10.1016/j.heliyon.2018. [Google Scholar] [CrossRef]
Cite This Article
Copyright © 2024 The Author(s). Published by Tech Science Press.This work is licensed under a Creative Commons Attribution 4.0 International License , which permits unrestricted use, distribution, and reproduction in any medium, provided the original work is properly cited.


Submit a Paper
Propose a Special lssue
View Full Text
Download PDF
Downloads
Citation Tools